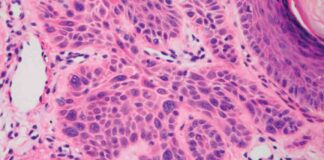
Starving Cancer Cells: Scientists’ Approach to Treating Cancer news-22092024-045828

Idaho School District Implements New Law Requiring Parental Consent for Student Medical Treatment
In a move that has sparked debate and controversy, the Boise School District in Idaho has recently implemented a new law mandating parental consent for non-life-threatening medical services provided to students. Under Senate Bill 1329, which went into effect in July, school nurses and staff are now required to obtain permission from a parent before administering basic medical care such as Band-Aids, headache medicine, and mental health check-ins. This significant change has raised concerns among parents, educators, and healthcare professionals alike.
Parental Consent Policy Update
The Boise School District wasted no time in informing parents about the new law, sending out a memo detailing the updated parental consent policy. According to NBC affiliate KTVB of Boise, the district outlined the specific medical services for which consent is now required, including routine first-aid, Band-Aids, mental health check-ins, and over-the-counter headache medicine. The memo emphasized that these services cannot be provided to students without the proper consent form on file.
Response from School Boards Association
The Idaho School Boards Association has weighed in on the issue, acknowledging the challenges presented by the new law. Executive director Misty Swanson emphasized that while it may seem excessive to require explicit permission for something as simple as applying a Band-Aid, school districts and charter schools must adhere to the statute outlined in SB 1329 to avoid potential civil penalties. Swanson urged districts to obtain consent even for minor medical interventions, citing the importance of compliance with the law.
Navigating Gray Areas
Despite the clear mandate for parental consent, the Boise School District has advised staff to exercise their best judgment in situations where obtaining consent in a timely manner is not feasible. This approach reflects the delicate balance between following the law and ensuring that students receive necessary medical care when needed. Other school districts, such as the West Ada School District, have similarly emphasized the importance of parental consent while operating with heightened awareness in light of the recent legislation.
Challenges and Implications
The implementation of SB 1329 has presented challenges for educators, healthcare providers, and parents alike. While the intent of the law is to protect parental rights and ensure transparency in medical care provided to students, it has also raised questions about the practical implications of obtaining consent for routine medical services. Some critics argue that the law may hinder timely access to basic healthcare for students, while others contend that it is a necessary safeguard to protect children’s well-being.
Navigating the Legal Landscape
School districts across Idaho are grappling with how to navigate the legal landscape created by SB 1329. While some have taken proactive measures to update their parental consent policies, others are still in the process of determining the best approach to compliance. The Idaho School Boards Association has provided guidance to districts on how to interpret and apply the law, emphasizing the importance of following the statute to avoid potential penalties.
Parental Involvement and Communication
One of the key aspects of the new law is the emphasis on parental involvement in decisions regarding their child’s medical care. By requiring consent for a wide range of non-life-threatening medical services, the law seeks to empower parents to make informed choices about their child’s health. Effective communication between schools and parents is crucial in ensuring that families understand the implications of the law and are able to provide consent when necessary.
Balancing Safety and Access
As school districts grapple with the implementation of SB 1329, they are faced with the challenge of balancing student safety with access to necessary medical care. While the law aims to protect children and uphold parental rights, there is a fine line between ensuring compliance and ensuring that students receive timely and appropriate medical attention. Educators, healthcare providers, and parents must work together to navigate these complexities and uphold the well-being of students.
Looking Ahead
As the Boise School District and other school districts in Idaho adjust to the new requirements of SB 1329, there is a need for ongoing dialogue and collaboration among stakeholders. By fostering open communication, addressing concerns, and finding common ground, schools can navigate the legal landscape while prioritizing the health and well-being of students. The implementation of the new law may present challenges, but it also offers an opportunity for schools to reaffirm their commitment to student safety and parental involvement in medical decision-making.